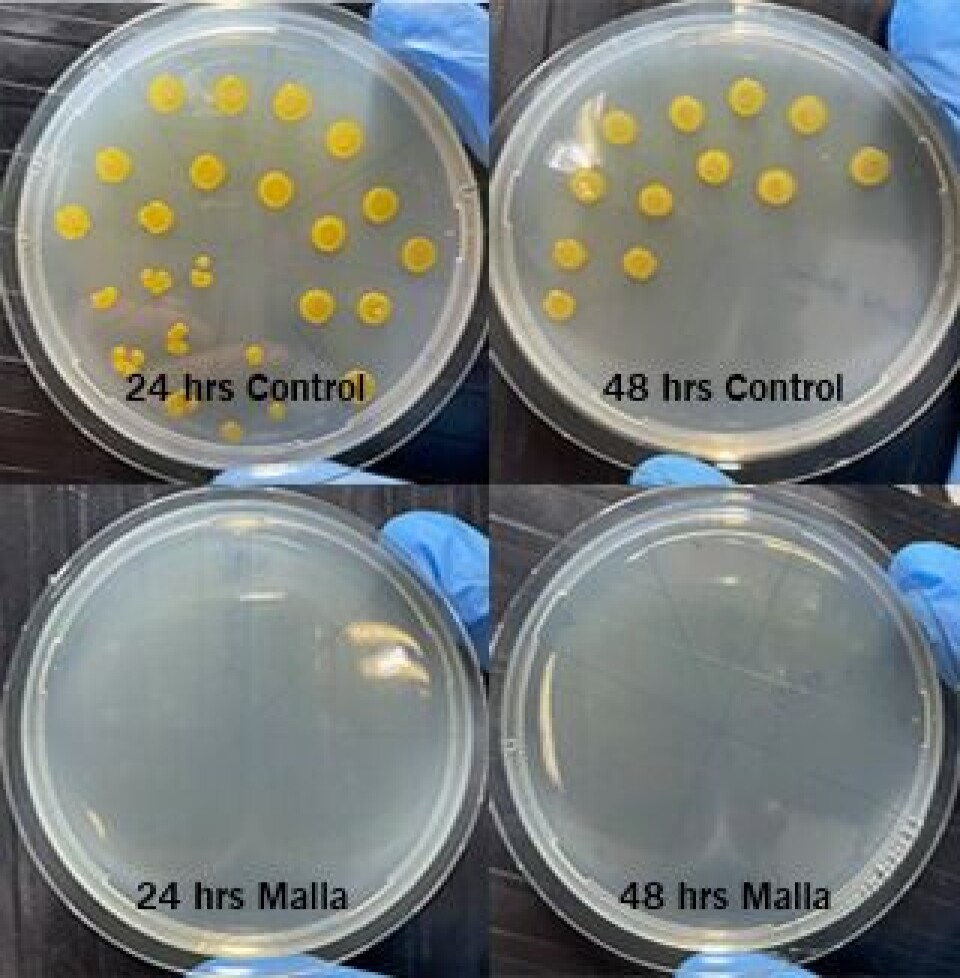
Cermaq tester V2 nøter og luseskjørt mot bakterielle patogener

Cermaq tester V2 nøter og luseskjørt mot bakterielle patogener
Garware og Cermaq samarbeider om å finne nye verktøy for å bekjempe bakterier som forårsaker tenacibaculose i lakseoppdrett. En teori er at patogene bakterier koloniserer plastoverflater som nett, flytering, bøyer etc. De første laboratorieresultatene utført av Cermaq og Garware viser at de nye V2-fibrene reduserer antall bakterier med 99,9 % sammenlignet med vanlig HDPE.
Denne artikkelen er tre år eller eldre.
Tre arter av marine bakterier i slekten Tenacibaculum: Tenacibaculum finnmarkense, Tenacibaculum dicentrarchi og Tenacibaculum Maritimum er kjent for å forårsake tenacibaculose i atlantisk laks. Tenacibaculose er en ulcerøs sykdom preget av sår i skinn og munn, flossende finner og spord. De siste årene har det vært kjent for å være et betydelig fiskehelseproblem. Tenacibaculose kan forårsake stor dødelighet i oppdrettsanlegg. Det er store tap på grunn av høyt svinn, redusert vekst og tidlig slakting. Tenacibaculum finnmarkense er også assosiert med vintersår i Norge, noe som er et problem for større fisk. Vintersår fører til redusert fiskevelferd og nedgradering fra superior til produksjon og dered redusert pris og tapte inntekter. Mattilsynet sier at noen slakteri rapporterer at så mye som 30% av fisken nedgraderes på grunn av sår. Det er anslått at ca 10-20 % av oppdrettslaksen i Nord-Norge påvirkes i de kalde månedene av året.
I Chile er Salmonid Rickettsial Septicemia (SRS) et av de største sykdomsproblemene i den chilenske næringen med økonomiske tap på flere millioner dollar enkelte år. SRS er forårsaket av bakterien Piscirickettsia salmonis (P. Salmonis).
Det er fortsatt et betydelig kunnskapshull om bakterielt mangfold, spredning, og patogenitet til Tenacibaculum-artene. Tenacibaculose er ikke bare et tema for norsk havbruk, men et problem for oppdrettsnæringen globalt. Det er derfor behov for å utvikle verktøy for å redusere problemet.
Garware Technical Fibres, verdens største produsent av laksenøter, introduserte V2 nøter og V2 luseskjørt for noen år siden. De er laget av et patentert V2 kompositt (HDPE/kobber) materiale. De innebygde antigroe-egenskapene til V2 teknologien oppnås ved langsom frigjøring av kobberioner fra overflaten av nettene når de kommer i sjøen. Forsøk utført i forskjellige regioner har vist at V2-nett har potensial til å redusere rengjøringsfrekvensen (spyling i sjø) med over 50%. V2 nøtene har 99,9% rent metallisk kobber i kompositten. Metallisk kober har vært kjent for å ha antimikrobielle egenskaper siden antikken. Forskning har vist at når vann lagres i et kobberkar i noen timer, gjennomgår det en såkalt oligodynamisk effekt, noe som betyr at kobberet nøytraliserer infeksjoner som forårsaker mikrober og sopp.
Garware sin FoU-avdeling har forsket på de antibakterielle og antivirale egenskapene til produktene laget av V2 komposittfibre og funnet ut at V2 har 99,98% antiviral egenskap når den testes mot MS2 Bacteriophage, samt 99,95% antibakteriell egenskap når den er testet mot Staphylococcus aureus ATCC 6538
Oppdagelsen gjorde at forskerteamet ville teste V2 nøter mot skadelige bakterier i lakseoppdrett.

Man bestemte seg for å teste teorien om bakteriekolonier som dannes på plastoverflater i oppdrett, for eksempel nøter. For å teste denne teorien og effekten av V2 mot skadelige bakteriearter, ble laboratorietester utført på ADL labs Chile. To bakteriearter, Tenacibaculum dicentrarchi og Piscirickettsia salmonis, kjent for å ha betydelig påvirkning på lakseoppdrett, ble brukt til laboratorieforsøkene. Bakterien ble testet mot V2 komposittfibre og mot vanlige HDPE fibre som kontroll.
(Kontroll fibrene og V2 fibrene ble plassert i en standard bakteriesuspensjon av P. salmonis (strain PM-15972) og T. dicentrarchi (strain PM-90951), justert i begge tilfeller til en 0,5 McFarland som tilsvarer 108 kolonidannende enheter (cfu)/ml. Bakteriene ble inkubert ved 18 ° C i 1, 4, 24 og 48 timer (figur 1).)
Prøver ble tatt fra glassene, og sådd ut på marine agarplater med T. dicentrarchi og Ps agar for P. salmoni. Dette ble gjort for å bestemme de gjenværende kolonitallene etter eksponering ved ulike tidsintervaller. Resultatene viste at V2 fibre dreper 99,9% av både T. dicentrarchi og P. salmonis innen 4 timer og 100% innen 24 timer.
Cermaq har utført en lignende test på V2 og kontrollfibre mot T. finnmarkense og T. maritimum og har funnet tilsvarende resultater i sitt laboratorium.
Resultatene i småskalaforsøk har vært veldig oppmuntrende. Det tyder på at V2 nøter og V2 luseskjørt kan være potensielle verktøy for å bekjempe det voksende tenacibaculosis problemet. Sammen med Cermaq pågår det nå fullskala forsøk med V2 nøter og luseskjørt i sjøen for å se om en kan få tilsvarende effekt i komersiellt oppdrett.